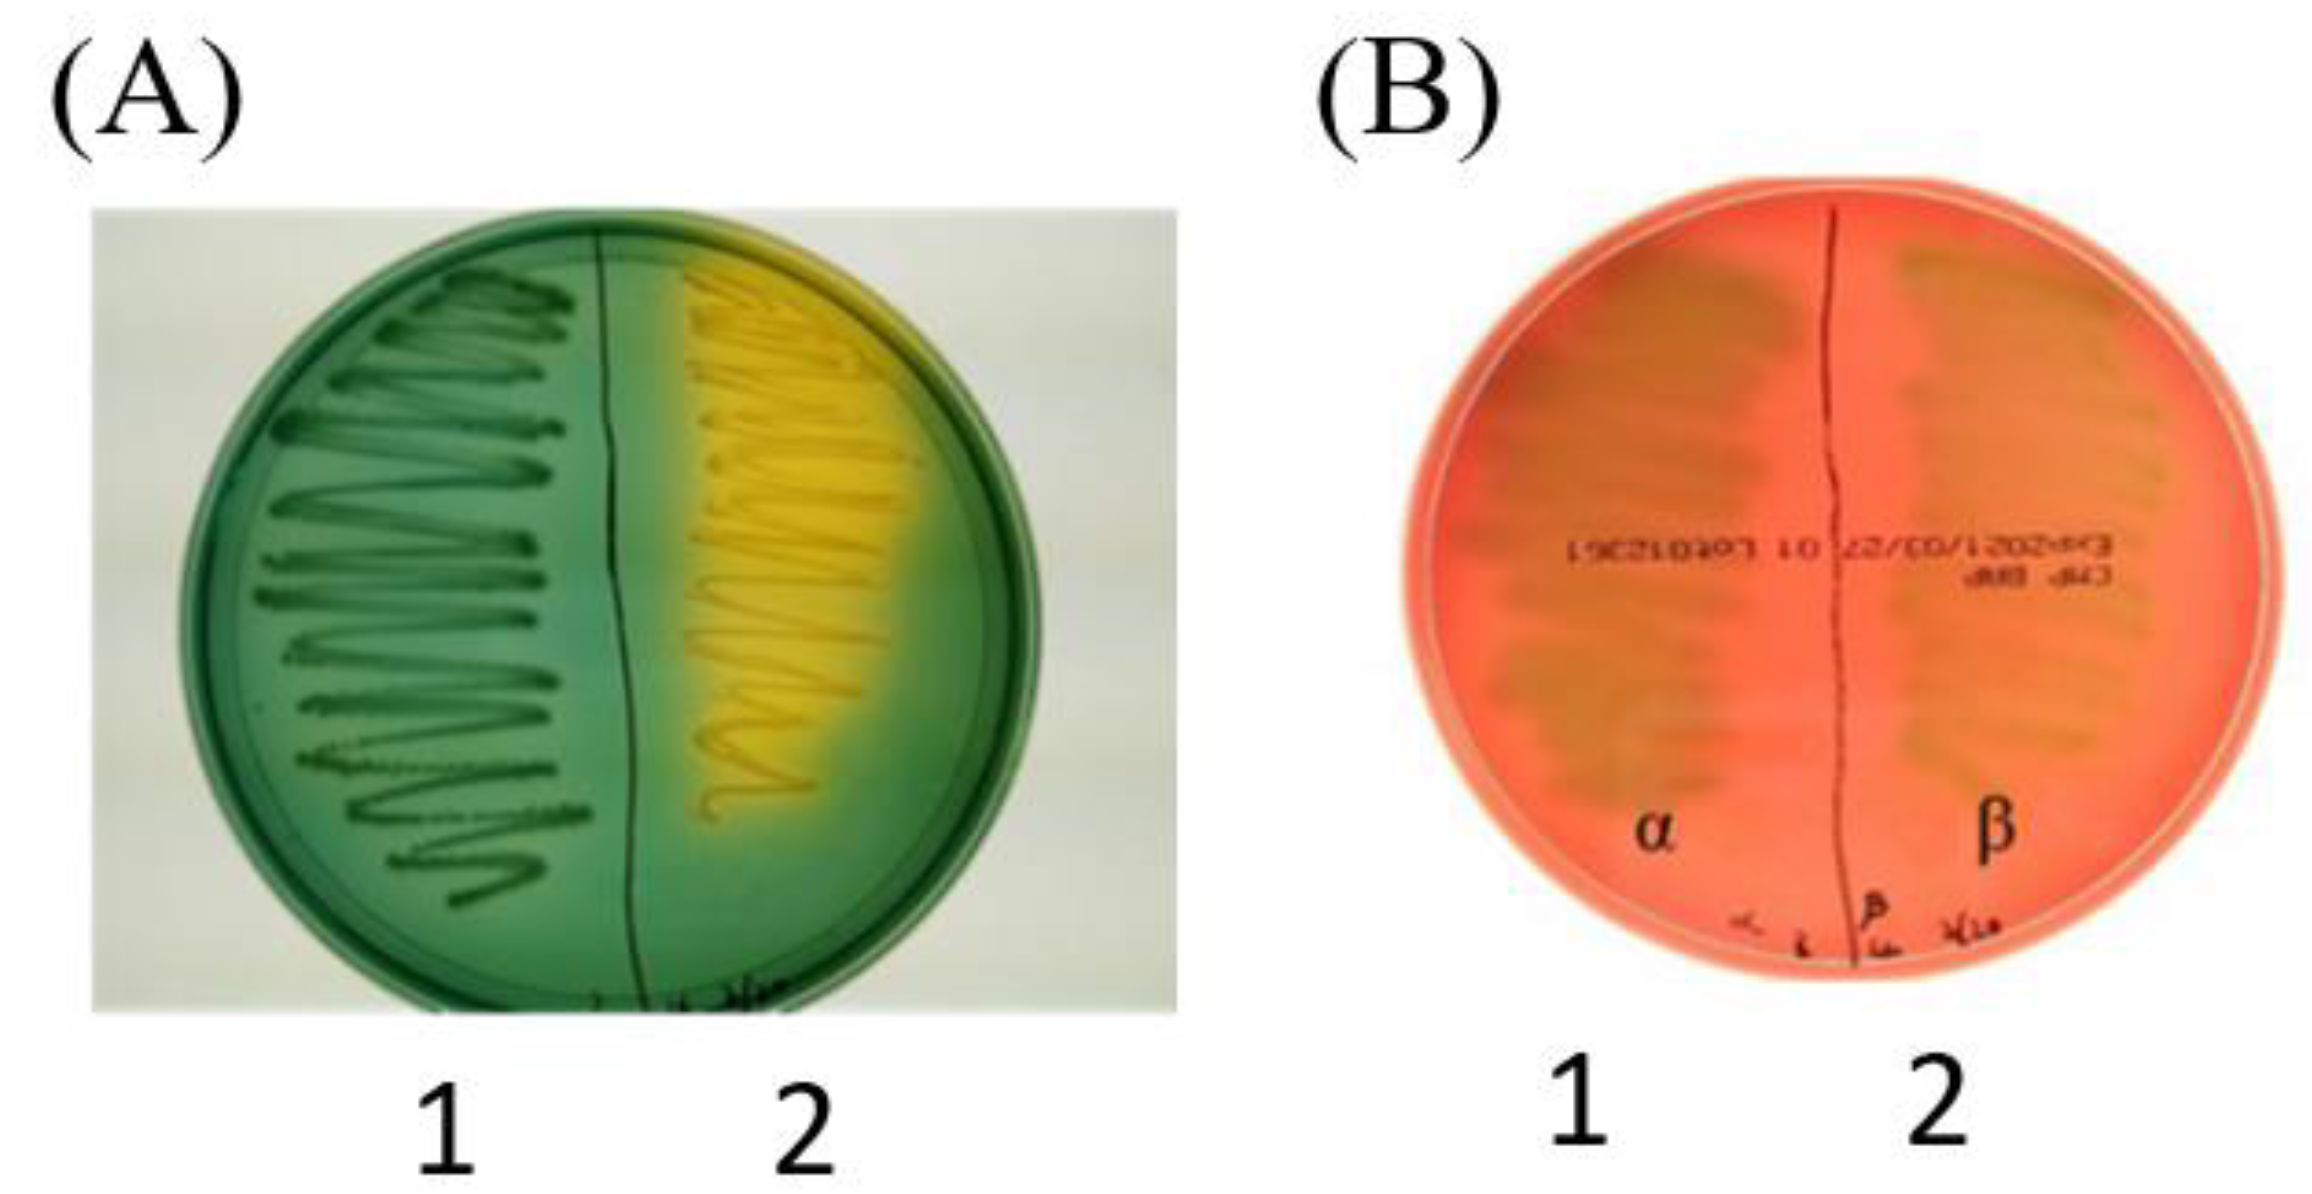
Jmse 10 00625 g002 Jmse 10 00625 g002

Inactivated Whole Vaccine Inhibits Lethal Vibrio harveyi Infection in Oplegnathus punctatus
Abstract
1. Introduction
2. Materials and Methods
2.1. Fish
2.2. Screening and Isolation of Pathogenic Bacteria
2.3. Bacteriological Investigation and 16S rDNA Sequencing
2.4. Antibacterial Susceptibility Test
2.5. Intraperitoneal Injection Challenge Assay
2.6. Vaccine Preparation
2.7. Efficacy Trial
2.8. Statistical Analysis
3. Results
3.1. Screening and Isolation of Pathogenic Bacteria
3.2. 16S rDNA Sequencing and Biochemical Characterization
3.3. Susceptibility to Antibiotics
3.4. Lethality Tests
3.5. Protection against V. harveyi in O. punctatus Induced by Inactivated Vaccine
4. Discussion
5. Conclusions
Author Contributions
Funding
Institutional Review Board Statement
Informed Consent Statement
Data Availability Statement
Acknowledgments
Conflicts of Interest
References
- Asih, Y.; Mahardika, K.; Susanto, B. Fasting In Hybrid Grouper Epinephelus Fuscoguttatus X Epinephelus Lanceolatus In Relation To Proximate Contents, Growth And Feed Efficiency. Mar. Res. Indones. 2019, 44, 11–17. [Google Scholar] [CrossRef]
- Liu, X.; Li, X.; Du, X.; Sun, M.; Wang, X.; Li, W.; Zhai, J.; Liu, J.; Yu, H.; Zhang, Q. Spotted knifejaw (Oplegnathus punctatus) MyD88: Intracellular localization, signal transduction function and immune responses to bacterial infection. Fish Shellfish. Immunol. 2019, 89, 719–726. [Google Scholar] [CrossRef] [PubMed]
- Yusuf, Y.; Seah, Y.; Izarenah, M.; Nie, L. First record of Spotted Knifejaw, Oplegnathus punctatus (Temminck & Schlegel, 1844) (Oplegnathidae) in the southern South China Sea. Check List 2021, 17, 1195–1198. [Google Scholar] [CrossRef]
- Zhang, K.; Liu, X.; Li, X.; Liu, Y.; Yu, H.; Liu, J.; Zhang, Q. Antibacterial functions of a novel fish-egg lectin from spotted knifejaw (Oplegnathus punctatus) during host defense immune responses. Dev. Comp. Immunol. 2020, 111, 103758. [Google Scholar] [CrossRef] [PubMed]
- Kawato, Y.; Yamashita, H.; Yuasa, K.; Miwa, S.; Nakajima, K. Development of a highly permissive cell line from spotted knifejaw (Oplegnathus punctatus) for red sea bream iridovirus. Aquaculture 2017, 473, 291–298. [Google Scholar] [CrossRef]
- Rijkers, G.T.; Van Oosterom, R.; Van Muiswinkel, W.B. The immune system of cyprinid fish. Oxytetracycline and the regulation of humoral immunity in carp (Cyprinus carpio). Vet. Immunol. Immunopathol. 1981, 2, 281–290. [Google Scholar] [CrossRef]
- Bojarski, B.; Kot, B.; Witeska, M. Antibacterials in Aquatic Environment and Their Toxicity to Fish. Pharmaceuticals 2020, 13, 189. [Google Scholar] [CrossRef]
- Thu Lan, N.G.; Salin, K.R.; Longyant, S.; Senapin, S.; Dong, H.T. Systemic and mucosal antibody response of freshwater cultured Asian seabass (Lates calcarifer) to monovalent and bivalent vaccines against Streptococcus agalactiae and Streptococcus iniae. Fish Shellfish. Immunol. 2021, 108, 7–13. [Google Scholar] [CrossRef]
- Jorgensen, J.H.; Ferraro, M.J. Antimicrobial susceptibility testing: A review of general principles and contemporary practices. Clin. Infect. Dis. 2009, 49, 1749–1755. [Google Scholar] [CrossRef] [PubMed]
- Pang, L.; Zhang, X.-H.; Zhong, Y.; Chen, J.; Li, Y.; Austin, B. Identification of Vibrio harveyi using PCR amplification of the toxR gene. Lett. Appl. Microbiol. 2006, 43, 249–255. [Google Scholar] [CrossRef]
- Li, M.; Zhang, R.; Fan, G.; Xu, W.; Zhou, Q.; Wang, L.; Li, W.; Pang, Z.; Yu, M.; Liu, Q.; et al. Reconstruction of the Origin of a Neo-Y Sex Chromosome and Its Evolution in the Spotted Knifejaw, Oplegnathus punctatus. Mol. Biol. Evol. 2021, 38, 2615–2626. [Google Scholar] [CrossRef]
- Du, X.; Liu, X.; Zhang, K.; Liu, Y.; Cheng, J.; Zhang, Q. Discovery and functional characterization of microRNAs and their potential roles for gonadal development in spotted knifejaw, Oplegnathus punctatus. Comp Biochem. Physiol. Part D Genom. Proteom. 2018, 28, 1–8. [Google Scholar] [CrossRef] [PubMed]
- Li, P.Z.; Cao, D.D.; Liu, X.B.; Wang, Y.J.; Yu, H.Y.; Li, X.J.; Zhang, Q.Q.; Wang, X.B. Karyotype analysis and ribosomal gene localization of spotted knifejaw Oplegnathus punctatus. Genet. Mol. Res. 2016, 15, 1–11. [Google Scholar] [CrossRef]
- Shimada, Y.; Nokubi, K.; Yamamoto, S.; Murata, O.; Kumai, H. Reproduction between Oplegnathus fasciatus and O. punctatus, and fertility of their interspecies. Fish. Sci. 2009, 75, 521–523. [Google Scholar] [CrossRef]
- Liu, X.; Li, X.; Peng, M.; Wang, X.; Du, X.; Meng, L.; Zhai, J.; Liu, J.; Yu, H.; Zhang, Q. A novel C-type lectin from spotted knifejaw, Oplegnathus punctatus possesses antibacterial and anti-inflammatory activity. Fish Shellfish. Immunol. 2019, 92, 11–20. [Google Scholar] [CrossRef]
- Shuang, F.; Luo, Y.; Xiong, X.-p.; Weng, S.; Li, Y.; He, J.; Dong, C. Virions proteins of an RSIV-type megalocytivirus from spotted knifejaw Oplegnathus punctatus (SKIV-ZJ07). Virology 2013, 437, 89–99. [Google Scholar] [CrossRef]
- Dong, C.; Weng, S.; Luo, Y.; Huang, M.; Ai, H.; Yin, Z.; He, J. A new marine megalocytivirus from spotted knifejaw, Oplegnathus punctatus, and its pathogenicity to freshwater mandarinfish, Siniperca chuatsi. Virus Res. 2010, 147, 98–106. [Google Scholar] [CrossRef]
- Manfredo Vieira, S.; Hiltensperger, M.; Kumar, V.; Zegarra-Ruiz, D.; Dehner, C.; Khan, N.; Costa, F.R.C.; Tiniakou, E.; Greiling, T.; Ruff, W.; et al. Translocation of a gut pathobiont drives autoimmunity in mice and humans. Science 2018, 359, 1156–1161. [Google Scholar] [CrossRef]
- Abidali, H.; Sheikh, M.; Abidali, M.; Abidali, A.; Farraji, H.S.; Berry, A.C. Enterococcus gallinarum Spontaneous Bacterial Peritonitis in an HCV Cirrhotic. Case Rep. Hepatol. 2015, 2015, 898235. [Google Scholar] [CrossRef][Green Version]
- Pujalte, M.J.; Sitjà-Bobadilla, A.; Macián, M.C.; Belloch, C.; Álvarez-Pellitero, P.; Pérez-Sánchez, J.; Uruburu, F.; Garay, E. Virulence and Molecular Typing of Vibrio harveyi Strains Isolated from Cultured Dentex, Gilthead Sea Bream and European Sea Bass. Syst. Appl. Microbiol. 2003, 26, 284–292. [Google Scholar] [CrossRef]
- Liu, P.-C.; Lin, J.-Y.; Chuang, W.-H.; Lee, K.-K. Isolation and Characterization of Pathogenic Vibrio harveyi(V. carchariae) From the Farmed Marine Cobia Fish Rachycentron canadum L. with Gastroenteritis Syndrome. World J. Microbiol. Biotechnol. 2004, 20, 495–499. [Google Scholar] [CrossRef]
- Zhang, X.-H.; He, X.; Austin, B. Vibrio harveyi: A serious pathogen of fish and invertebrates in mariculture. Mar. Life Sci. Technol. 2020, 2, 231–245. [Google Scholar] [CrossRef]
- Miller, V.L.; Mekalanos, J.J. Synthesis of cholera toxin is positively regulated at the transcriptional level by toxR. Proc. Natl. Acad. Sci. USA 1984, 81, 3471–3475. [Google Scholar] [CrossRef]
- DiRita, V.J. Co-ordinate expression of virulence genes by ToxR in Vibrio cholerae. Mol. Microbiol. 1992, 6, 451–458. [Google Scholar] [CrossRef]
- Miller, V.L.; Taylor, R.K.; Mekalanos, J.J. Cholera toxin transcriptional activator toxR is a transmembrane DNA binding protein. Cell 1987, 48, 271–279. [Google Scholar] [CrossRef]
- Miller, V.L.; Mekalanos, J.J. A novel suicide vector and its use in construction of insertion mutations: Osmoregulation of outer membrane proteins and virulence determinants in Vibrio cholerae requires toxR. J. Bacteriol. 1988, 170, 2575–2583. [Google Scholar] [CrossRef]
- Nguyen, H.T.; Thu Nguyen, T.T.; Tsai, M.-A.; Ya-Zhen, E.; Wang, P.-C.; Chen, S.-C. A formalin-inactivated vaccine provides good protection against Vibrio harveyi infection in orange-spotted grouper (Epinephelus coioides). Fish Shellfish. Immunol. 2017, 65, 118–126. [Google Scholar] [CrossRef]
- Wang, E.; Qin, Z.; Yu, Z.; Ai, X.; Wang, K.; Yang, Q.; Liu, T.; Chen, D.; Geng, Y.; Huang, X.; et al. Molecular Characterization, Phylogenetic, Expression, and Protective Immunity Analysis of OmpF, a Promising Candidate Immunogen Against Yersinia ruckeri Infection in Channel Catfish. Front. Immunol. 2018, 9, 2003. [Google Scholar] [CrossRef]

| Biochemical Panel | Vibrio harveyi |
|---|---|
| β-galactosidase (ONPG) | − |
| Arginine dihydrolase (ADH) | − |
| Lysine decarboxylase (LDC) | + |
| Ornithine decarboxylase (ODC) | + |
| Urease (URE) | + |
| Tryptophan deaminase (TDA) | − |
| Gelatinase (GEL) | − |
| Production of | |
| H2S | − |
| Indole (IND) | + |
| Acetoin (VP) | − |
| Fermentation of | |
| Citrate (CIT) | + |
| Glucose (GLU) | + |
| Mannose (MAN) | + |
| Inositol (INO) | − |
| Sorbitol (SOR) | − |
| Rhamnose (RHA) | − |
| Sucrose (SAC) | + |
| Melibiose (MEL) | − |
| Amygdaline (AMY) | + |
| Arabinose (ARA) | − |
| Code | Accession Number | PCR Identification | Identity (%) |
|---|---|---|---|
| 1 | MT510177_1 | Vibrio harveyi | 99.72 |
| 2 | CP046307.1 | Enterococcus gallinarum | 99.06 |
| Antibiotic | OTC | DO | UB | OA | AMC | AMP | MY | ERY | SP | |
|---|---|---|---|---|---|---|---|---|---|---|
| Sample | ||||||||||
| Vibrio harveyi—NTOU | R | S | S | S | S | R | R | R | R | |
| Enterococcus gallinarum—NTOU | R | R | R | R | R | R | R | R | R | |
| Bacterial Dose (CFU) | No. of Fish Dead at: | Cumulative Mortality (%) | ||
|---|---|---|---|---|
| 1 Day | 2 Days | 3–7 Days | ||
| 2.50 × 105 CFU/g BW | 8 | 0 | 0 | 80% |
| 1.25 × 105 CFU/g BW | 4 | 1 | 0 | 50% |
| 6.25 × 104 CFU/g BW | 0 | 0 | 0 | 0% |
| Control (PBS) | 0 | 0 | 0 | 0% |
Publisher’s Note: MDPI stays neutral with regard to jurisdictional claims in published maps and institutional affiliations. |
© 2022 by the authors. Licensee MDPI, Basel, Switzerland. This article is an open access article distributed under the terms and conditions of the Creative Commons Attribution (CC BY) license (https://creativecommons.org/licenses/by/4.0/).
Share and Cite
Lee, P.-T.; Huang, J.; Nan, F.-H. Inactivated Whole Vaccine Inhibits Lethal Vibrio harveyi Infection in Oplegnathus punctatus. J. Mar. Sci. Eng. 2022, 10, 625. https://doi.org/10.3390/jmse10050625
Lee P-T, Huang J, Nan F-H. Inactivated Whole Vaccine Inhibits Lethal Vibrio harveyi Infection in Oplegnathus punctatus. Journal of Marine Science and Engineering. 2022; 10(5):625. https://doi.org/10.3390/jmse10050625
Chicago/Turabian StyleLee, Po-Tsang, Jing Huang, and Fan-Hua Nan. 2022. "Inactivated Whole Vaccine Inhibits Lethal Vibrio harveyi Infection in Oplegnathus punctatus" Journal of Marine Science and Engineering 10, no. 5: 625. https://doi.org/10.3390/jmse10050625
APA StyleLee, P.-T., Huang, J., & Nan, F.-H. (2022). Inactivated Whole Vaccine Inhibits Lethal Vibrio harveyi Infection in Oplegnathus punctatus. Journal of Marine Science and Engineering, 10(5), 625. https://doi.org/10.3390/jmse10050625

